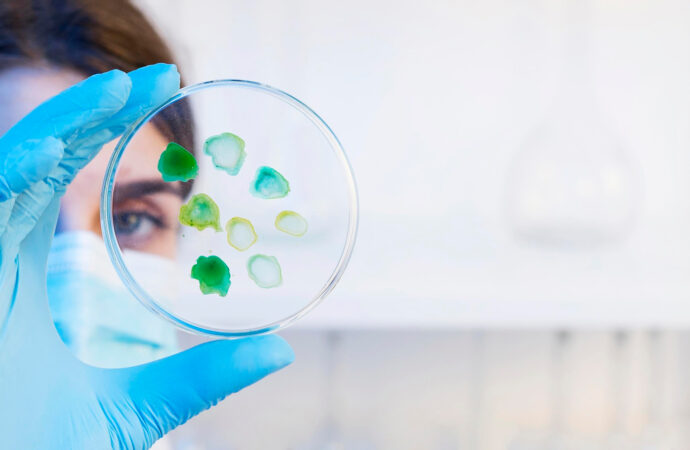
Dobry probiotyk na jelita: jak działa i jak go stosować? Przeczytaj rady dietetyka

Probiotyki to dziś jeden z wiodących tematów w kontekście zdrowia jelit. Niestety im więcej informacji, tym więcej mitów, ale także wątpliwości i pytań. Nie każdy produkt z bakteriami probiotycznymi jest probiotykiem. Nie każdy szczep działa tak samo. I nie każdy moment ich stosowania przyniesie realne efekty. Jak mądrze wybierać i stosować probiotyki, żeby naprawdę działały? Kiedy naprawdę mają sens? Czy naturalne probiotyki w ogóle istnieją, gdzie je znaleźć? Przeczytaj, co na ten temat mówi ekspert Well Be Studio Zdrowie, dietetyk kliniczny Sebastian Dzuła.
Co to jest probiotyk i jak działa?
Zacznijmy od podstaw. Nie każda bakteria probiotyczna to probiotyk. To, że na jogurcie jest napisane „zawiera żywe kultury bakterii”, nie oznacza, że działa jak probiotyk. Bo tak naprawdę to nim nie jest.
Zgodnie z definicją WHO, probiotyk to „żywy mikroorganizm, który podany w odpowiedniej ilości wywiera korzystny efekt zdrowotny u gospodarza”, czyli u Ciebie.
Warto także pamiętać, że prebiotyki, to nie bakterie. To swego rodzaju paliwo lub pokarm dla bakterii.
Jaki jest najlepszy probiotyk?
Probiotyki to nie magiczna pigułka. By miały realny, dobroczynny wpływ na zdrowie, muszą występować w odpowiedniej formie. Liczy się też dawka i moment podania.
Skuteczny, dobry probiotyk musi:
- być dobrze określony (rodzaj, gatunek, szczep),
- mieć potwierdzone działanie w badaniach klinicznych,
- przeżyć drogę przez układ pokarmowy,
- być podany w odpowiedniej dawce.
Nie każdy produkt z bakteriami probiotycznymi rzeczywiście działa jak probiotyk, nie każdy szczep przynosi takie same efekty, a moment ich stosowania ma duże znaczenie dla skuteczności.
Czy to oznacza, że bakterie, które znajdziemy w naturalnych produktach, nie są nam do niczego potrzebne? Odpowiedź brzmi: nie. Jak najbardziej mają realny wpływ na mikrobiotę, jelita, cały układ pokarmowy.
Czytaj: Jakie produkty niszczą jelita? Dietetyk wyjaśnia, czego nie jeść i dlaczego
Jak wybrać dobry probiotyk na jelita?
Nie wystarczy zerknąć na kolorową etykietę i ucieszyć się z napisu „zawiera probiotyki”. To jeszcze niczego nie gwarantuje. Liczy się coś więcej: konkretne informacje o szczepach, ich dawce i udowodnionym działaniu. To one decydują, czy produkt faktycznie wesprze Twoje jelita, czy będzie jedynie marketingowym hasłem. Jak więc odróżnić realny probiotyk od chwytliwej obietnicy? Ważne są różne kwestie.
Szczep bakterii probiotycznych
Na opakowaniu powinno być dokładnie określone: rodzaj, gatunek i szczep (np. Lactiplantibacillus plantarum 299v). Brzmi skomplikowanie, ale tylko wtedy masz pewność, że kupujesz prawdziwy probiotyk, a nie „jakieś bakterie”.
Dawka bakterii probiotycznych
Dawka musi być sprecyzowana i podana w jednostkach CFU – czyli tworzących kolonię bakterii. W zależności od szczepu i celu stosowania, zazwyczaj jest to od 1 do 10 miliardów CFU dziennie, choć bywa też więcej.
Czytaj: Probiotyki na jelita – jak je wybierać i stosować, żeby naprawdę działały? Zobacz, co radzi dietetyk
Cel stosowania
Żaden probiotyk nie działa na wszystko. Różne szczepy mają różne zastosowania:
- niektóre przy antybiotykoterapii,
- inne przy IBS (zespole jelita drażliwego),
- jeszcze inne przy biegunkach infekcyjnych.
Dobór szczepu musi być dopasowany do konkretnego problemu – inaczej suplementacja może być nieskuteczna.
Forma probiotyku
Forma ma znaczenie: kapsułki odporne na sok żołądkowy zwiększają szansę, że bakterie dotrą do jelit. Niektóre suplementy muszą być przechowywane w lodówce – sprawdź zalecenia producenta.
Termin ważności i przechowywanie
Bakterie muszą być żywe, żeby działać. Zwracaj uwagę na datę przydatności, sposób przechowywania i temperaturę w transporcie. Praktyczna rada: latem unikaj odbioru probiotyków z automatów przy wysokich temperaturach – mogą stracić swoje właściwości. Niektóre firmy wprowadzają blokadę wysyłki, gdy temperatura jest zbyt wysoka, by chronić mikroorganizmy.
Praktyczna rada. Latem, gdy panują bardzo wysokie temperatury, nie zamawiaj probiotyków do automatów z punktem odbioru. Jest bardzo duże ryzyko, że — mówiąc krótko — zagotują się i stracą swoje cenne właściwości. Niektóre sklepy czy producenci nie wysyłają swoich probiotyków, gdy panują takie warunki. Właśnie z myślą o tym, aby preparaty nie straciły na jakości.

Jak wybrać najlepszy probiotyk dla siebie?
Zapamiętaj: nie ma jednego, najlepszego probiotyku. Zamiast pytać „jaki probiotyk jest najlepszy”, lepiej zapytać: jaki szczep ma udowodnione działanie w moim przypadku?
Dobranie dobrego probiotyku to jak dobranie pokrowca na telefon. Nie wystarczy, że „jakiś tam pasuje” — musisz znać model, rozmiar i konkretne potrzeby. Probiotyk też musi być dopasowany: konkretny szczep, odpowiednia dawka, właściwy czas stosowania i cel.
Inny działa przy zaparciach, inny przy biegunce po antybiotyku, a jeszcze inny przy SIBO czy IBS. Jeśli nie wiesz jak to zrobić, to nic dziwnego — to nie jest takie proste. Najlepiej skonsultuj się z lekarzem lub dietetykiem, który dobierze konkretny probiotyk skrojony do Twoich potrzeb. I właśnie dlatego nie istnieje „najlepszy probiotyk dla każdego”.
Czytaj: Produkty, które niszczą zdrowe jelita. Sprawdź, co radzi dietetyk
Kiedy i jak stosować probiotyk?
Nie każdy moment jest dobry na rozpoczęcie suplementacji probiotykiem, a sposób jego przyjmowania może przesądzić o skuteczności. Warto wiedzieć, kiedy organizm najbardziej potrzebuje wsparcia i jak stosować probiotyk, by naprawdę działał.
Probiotyki a antybiotykoterapia
Kiedy stosować probiotyk przy antybiotykoterapii? Ze świeżego artykułu z tego roku wnioski są jasne: probiotyki mogą być skutecznym wsparciem przy antybiotykoterapii, ale nie działają jak magiczna pigułka. Skuteczność zależy od szczepu, dawki i kontekstu klinicznego. Dobrze udokumentowaną skuteczność mają Lactobacillus rhamnosus GG (LGG) oraz Saccharomyces boulardii CNCM I-745.
Dowiedziono, że Saccharomyces boulardii, stosowany w dawce 1,8–10 miliardów żywych komórek na dobę równolegle z antybiotykiem i przez około 7 dni po (łącznie ~14–21 dni), obniżał ryzyko biegunek o ok. 50%, zarówno u dzieci, jak i dorosłych.
W przestrzeni medialnej można czasami spotkać się z zaleceniem, by probiotyk trzeba stosować nawet pół roku po antybiotyku. Nie jest to prawdą. Nie ma na to odpowiednich dowodów naukowych. Niemniej jednak oczywiście po antybiotyku warto zadbać o swoje jelita, ale są na to inne, skuteczne sposoby.
Probiotyk na jelita w zespole jelita drażliwego
W przypadku powszechnego zespołu jelita drażliwego, obiecującym wydaje się być probiotyk Lactiplantibacillus plantarum 299v (wcześniej zwanym Lactobacillus plantarum 299v,
W randomizowanym badaniu na ponad 200 pacjentach z IBS (stwierdzone według kryteriów rzymskich) suplementacja 10 mld CFU dziennie przez 4 tygodnie skutkowała:
- znacznie większą częstotliwością wypróżnień, zmniejszając zaparcia,
- zmniejszeniem wzdęć, bólu brzucha i uczucia niepełnego wypróżnienia
Dodatkowo można znaleźć probiotyki na IBS ze szczepem Bifidobacterium infantis 35624, który po 8 tygodniowej suplementacji skutkował o ≥30 % redukcją symptomów IBS, oraz znacznie mniejszym wzdęciem i bólem brzucha
Ale pamiętaj — probiotyk to nie multiwitamina. Nie każdy musi go brać codziennie. Często lepszy efekt daje odpowiednia dieta i prebiotyki.
Czytaj: SIBO – choroba jelit, która wpływa na całe ciało. Jak ją rozpoznać i leczyć?
Co to są prebiotyki?
Bez prebiotyków nawet najlepszy probiotyk długo nie przetrwa. To właśnie prebiotyki są pożywką dla bakterii jelitowych. Co nimi jest?
- Błonnik rozpuszczalny z warzyw, owoców, strączków,
- inulina i fruktooligosacharydy (FOS) obecna w cykorii, cebuli, porach, czosnku,
- oporna skrobia, którą można znaleźć np. w niedojrzałych bananach,
- beta-glukany, obecne w płatkach owsianych i jęczmieniu.
Czytaj: Owsianka to idealne śniadanie czy nie? Dietetyk rozwiewa wątpliwości

Naturalne probiotyki – jakie są najlepsze źródła?
Warto pamiętać, że probiotyki to nie tylko suplementy z apteki. Kiszonki, fermentowane produkty spożywcze, choć może nie zawierają konkretnych, wyliczonych szczepów, także wspierają mikrobiotę.
Na świecie spożywa się nawet 5000 różnych fermentowanych produktów, a w Polsce zazwyczaj kilka, może kilkanaście. Co warto włączyć do diety?
Czy bakterie probiotyczne, pochodzące z naturalnych produktów są nam potrzebne? Odpowiedź brzmi: tak, ponieważ mają realny wpływ na mikrobiotę, jelita i cały układ pokarmowy.
Czytaj: Produkty na zdrowe jelita. Co warto jeść? Rekomendacje eksperta
Kefir – babcina mądrość w nowoczesnym wydaniu
Nasze babcie miały rację: kefir działa na brzuszek, a nauka potwierdza jego właściwości.
Kefir to coś więcej niż kwaśne mleko. To naturalnie złożony produkt, który zawiera ponad 50 gatunków bakterii i drożdży. Badania wskazują, że dzięki temu ma właściwości: przeciwzapalne, przeciwnowotworowe, antyoksydacyjne, obniżające cholesterol, łagodzące zaparcia, wspierające odporność, a nawet zmniejszające ryzyko otyłości i stłuszczenia wątroby.
Co wyróżnia kefir? Wysoka odporność mikroorganizmów na trawienie i ich zdolność do kolonizacji jelita, co pozwala realnie modulować skład mikrobioty i mykobioty (flory grzybiczej jelit). Choć potrzebujemy jeszcze badań, jedno jest pewne — kefir to jeden z najmocniejszych naturalnych sposobów wsparcia jelit, jaki znajdziesz w sklepowej lodówce.
Jogurt naturalny dobry na jelita
A co z jogurtem naturalnym? To jeden z tych produktów, które wielu traktuje jako „naturalny probiotyk”. I choć nie każdy jogurt spełnia definicję probiotyku, to badania pokazują, że jego regularne spożywanie realnie wpływa na mikrobiom i zdrowie metaboliczne.
W analizie ponad 1000 rodzeństw bliźniaczych w Wielkiej Brytanii wykazano, że osoby jedzące jogurt miały mniej tłuszczu wisceralnego, czyli tego w okolicy brzucha, który otacza narządy, a w ich jelitach wykryto wyższy poziom korzystnych nam bakterii z rodzaju Streptococcus i Bifidobacterium, dokładnie tych, wykorzystywanych w produkcji jogurtów. Czyli jogurt to nie magiczna kapsułka, ale codzienny wartościowy dodatek, który może realnie poprawiać funkcjonowanie jelit i metabolizmu.
Kiszona kapusta na jelita i odporność
Jest z nami od blisko 2 i pół tysiąca lat, dostarcza polifenoli, witaminy K, witaminy C, dzięki czemu ratowała marynarzy przed szkorbutem, a przy tym ma mało kalorii, o czym mowa?
Analiza ponad 90 lat badań pokazuje, że spożywanie kiszonek może wspomagać trawienie, układ odpornościowy, a nawet działać antynowotworowo. Jednak — i to jest praktyczna uwaga — u niektórych osób zdarzają się negatywne reakcje na ten produkt, a nawet reakcje zapalne jelit i biegunki, szczególnie przy dużych porcjach lub wrażliwym przewodzie pokarmowym.
Kapusta kiszona najlepiej działa w umiarkowanej dawce: 1–2 łyżki dziennie to solidny start. Warto zacząć od małych porcji i obserwować reakcję organizmu.
Z ogórkami kiszonymi będzie podobnie: są to zdrowe produkty, natomiast pamiętajmy przy tym, że dostarczają sporych ilości soli, co może być bardzo ważną informacją dla osób z nadciśnieniem tętniczym.
Probiotyki na jelita – podsumowanie
Probiotyki mogą działać, ale tylko wtedy, gdy są dobrane z głową. Czasem więcej korzyści — niż kolejny suplement — przynosi codzienna porcja kiszonek, błonnika i prebiotyków.
Codzienna dieta bogata w prebiotyki to realne wsparcie dla mikrobiomu — i coś, co działa długofalowo nie tylko na chwilę. Wyobraź sobie, że samodzielnie możesz „wyhodować” bakterie probiotyczne w swoich jelitach. To będzie możliwe, gdy zadbasz o odpowiednią ilość błonnika. Dlatego jeśli chcesz zadbać o jelita, zacznij od swojego jadłospisu. A jeśli sięgasz po probiotyk, to z konkretnym celem i odpowiednim składem.
Źródła:
- Modern perspectives on the health benefits of kefir in next generation sequencing era: Improvement of the host gut microbiota
- Regular Consumption of Sauerkraut and Its Effect on Human Health: A Bibliometric Analysis
- Probiotics as Support for Antibiotic Therapy: Benefits and Risks
- Saccharomyces boulardii to Prevent Antibiotic-Associated Diarrhea: A Randomized, Double-Masked, Placebo-Controlled Trial
- Clinical trial: Lactobacillus plantarum 299v (DSM 9843) improves symptoms of irritable bowel syndrome

Twój adres e-mail nie zostanie opublikowany. Wymagane pola są oznaczone *